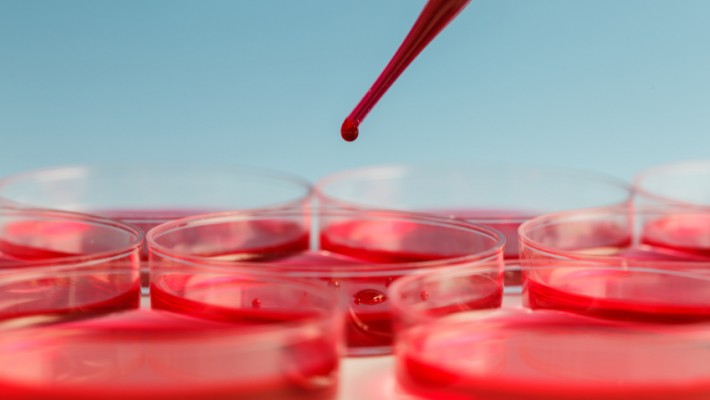

O super computador da IBM já mostrou o seu poder um pouco por toda a parte. Ganhou um concurso televisivo e até derrotou os mais brilhantes cérebros humanos no xadrez. Contudo, se há um feito...

O super computador da IBM já mostrou o seu poder um pouco por toda a parte. Ganhou um concurso televisivo e até derrotou os mais brilhantes cérebros humanos no xadrez. Contudo, se há um feito...